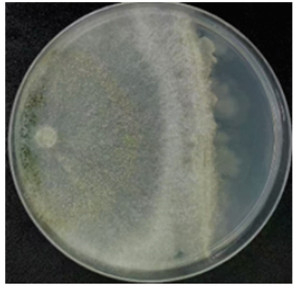

-
开放科学(资源服务)标识码(OSID):

-
水稻纹枯病是由立枯丝核菌(Rhizoctonia soalni)引起的土传真菌病害,在秧苗期至穗期均可发生,可造成严重减产。目前海南在生产上对于水稻纹枯病主要采用化学农药、微生物源农药井冈霉素及活体微生物农药蜡质芽孢杆菌等进行防治。木霉[1-2]、芽孢杆菌[3]等生防菌株对水稻纹枯病有较好的防效,两者组合作为生防菌剂的应用潜力大[4],将其共培养成复合微生物菌剂防治水稻纹枯病值得探索。
芽孢杆菌类生防菌能拮抗大部分真菌,但有些木霉菌与芽孢杆菌菌株能亲和共培养成复合菌群,且防效提高[5]。一些木霉复合菌剂比单一微生物对植物的促生和控制病害的效果更好[6]。木霉与芽孢杆菌共培养后可诱导木霉菌产生拮抗和促生物质、免疫性物质、生长调控物等,对小麦赤霉病的防效高于两种菌分别培养再组合的发酵产物,且有增产作用[7]。棘孢木霉HG1与枯草芽孢杆菌tpb55通过固态共培养发酵得到新代谢产物harziandione,对烟草病害防效提高[8]。木霉PT-29与枯草芽孢杆菌S-16液体共发酵,对马铃薯枯萎病的防效达到73.44%,高于单一菌株发酵产物的防效[9]。
可湿性粉剂(WP)是商品微生物农药中的主要剂型。从实验室保存的菌种中,筛选出1株对稻瘟病菌及纹枯病菌抑菌强、生长快且产孢多的LN006菌株,从分子水平鉴定其为短梗木霉Trichoderma breve;1株对稻瘟病菌抑菌强、中等抑制纹枯病菌、白叶枯病菌且对水稻有促生效果的细菌ZJ菌株,鉴定为贝莱斯芽孢杆菌Bacillus velezensis。本研究采用固体共培养技术发酵生产T. breve LN006孢子和B. velezensis ZJ菌体及代谢产物组成的复合菌粉,辅以载体和润湿剂等辅剂,粉碎并混合成WP。通过测定不同种类及配比助剂的性能指标及与二菌之间的生物相容性,进行单因素优化试验,确定可湿性粉剂的组成,并验证其对水稻纹枯病的防病效果,为生产开发及田间应用奠定基础。
全文HTML
-
菌株:T. breve LN006、B. velezensis ZJ、水稻纹枯病原菌Hn-rs1由海南大学热带农林学院海南省绿色农用生物制剂创制工程研究中心分离保存。水稻种子:华浙优210,浙江勿忘农种业股份有限公司。固体PDA培养基(马铃薯200 g,葡萄糖20 g,琼脂20 g,蒸馏水1 000 mL);液体PDB培养基(马铃薯200 g,葡萄糖20 g,蒸馏水1 000 mL);液体LB培养基(10 g蛋白胨,5 g酵母粉,10 g氯化钠,蒸馏水1 000 mL);固体LB培养基(10 g蛋白胨,5 g酵母粉,10 g氯化钠,琼脂20 g,蒸馏水1 000 mL)。木霉—芽孢固体共发酵基质:稻壳40 g,玉米粉40 g,麦麸20 g,水40 mL,121 ℃高温灭菌20 min。载体:硅藻土、膨润土,天津市众联化学试剂有限公司;高岭土,河南恒源新材料有限公司;滑石粉,福晨(天津)化学试剂有限公司;白炭黑,山东优索化工科技有限公司。润湿剂:十二烷基苯磺酸钠、十二烷基硫酸钠、拉开粉、吐温-20,上海麦克林生化科技股份有限公司;吐温-80,西陇科学股份有限公司。分散剂:羧甲基纤维素钠,广东新如荣生物科技有限公司;木质素磺酸钙、聚乙烯醇,上海麦克林生化科技股份有限公司;BB4,禾大化学品(上海)有限公司;皂角粉,市售散装。紫外保护剂:维生素C,石药集团维生药业有限公司;氧化锌,凯邦生物科技有限公司;卵磷脂,河南嘉派生物科技有限公司;荧光素钠,天津登峰化学试剂厂;黄原胶,广东新如荣生物科技有限公司。药剂:4%井冈霉素水剂,桐庐汇丰生物科技有限公司。
-
将T. breve LN006转接于PDA培养基上活化,28 ℃培养,4 d大量产孢,无菌水冲洗孢子,并稀释为1×107 CFU/mL的种子液备用。在LB固体培养基上用枪头划取B. velezensis ZJ菌体并打入液体LB培养基中,37 ℃,180 r/min培养2 d后备用。在PDA固体培养基上用直径6 mm的打孔器取水稻纹枯病菌菌丝块并打入液体PDB培养基中,28 ℃,180 r/min培养7 d后备用。
-
T. breve LN006和B. velezensis ZJ在PDA平板上同时接种并进行对峙培养,观察两菌株共培养时的相容性。将T. breve LN006孢子悬浮液按照4%的接种量加入含木霉—芽孢固体共发酵基质的组培瓶中,于28 ℃恒温培养箱中静置培养2 d后,加入2%接种量的B. velezensis ZJ种子液,混匀,28 ℃共培养5 d。
发酵后的产物晾干后,用粉碎机粉碎5 s,共粉碎2次,2次粉碎间隔为5 min;之后将其过200目筛,得到菌粉备用。称取50 mg菌粉,用0.1%的吐温-80将其均匀分散,用血球计数板测量[10]孢子与菌体浓度,重复3次。
-
将5种载体分别与融化后的PDA、LB培养基混合,载体在培养基中的浓度为1 000 μg/mL,灭菌后制成平板。直径6 mm的打孔器取T. breve LN006菌丝块,接种到含不同载体的PDA平板上,3个重复,采用十字交叉法,以PDA培养基为对照,分别在第1、2、3 d后测量各个菌落的直径,计算菌丝生长速率、抑菌率[11]。将芽孢稀释到10-5涂布接种到上述含不同载体的LB平板中,在37 ℃培养箱中倒置培养,每种平板3个重复,计算菌落数,以LB固体培养基为对照,计算抑菌率[12]。选择出对T. breve LN006和B. velezensis ZJ影响较小的载体。
木霉菌菌丝生长速率(R生长)、 抑菌率(R抑菌)的计算公式:
式中:D最后为最后菌落直径;D最初为最初菌落直径;T菌落为菌落生长天数;D对照为对照菌落直径;D处理为处理菌落直径;R芽孢为芽孢杆菌抑菌率;N对照为对照菌落数;N处理为处理菌落数。
-
载体润湿时间的测定:采用《农药可湿性粉剂润湿性测定方法》 (GB/T 5451—2001)[13]的方法进行测定,记录每处理的润湿时间,设置3次重复。
载体悬浮率的测定:参照《农药悬浮率测定方法》 (GB/T 14825—2023)[14]的方法进行测定,记录每处理的悬浮率,设置3次重复。
-
称取硅藻土、高岭土、白炭黑、滑石粉、膨润土各2 g,放入洁净的烧杯中,使用胶头滴管将浓度为1.0×106 CFU/mL的木霉—芽孢孢子—菌体悬浮液逐滴加入不同的载体中,用玻璃棒搅拌至载体聚成一团,再称量吸附分生孢子浆后的总体质量,并计算载体对孢子—菌体悬浮液的吸附率,每个处理3次重复,选择出吸附率较高的载体,按公式计算载体吸附率(q)[15]:
式中:m1为吸附分生孢子浆后载体的质量(g);m0为吸附前吸附材料的质量(g)。
-
试验方法参照1.4.1。
-
将十二烷基硫酸钠、甲基纤维素、十二烷基苯磺酸钠、拉开粉、吐温-80、吐温-20分别按照3%的比例、木霉—芽孢菌粉20%的比例加入白炭黑中,混合均匀。参考GB/T 5451-2001[13]的方法进行不同润湿剂润湿时间的测定,每个处理3次重复,记录润湿时间,选出湿润性能较好的润湿剂。
-
试验方法参照1.4.1。
-
取不同分散剂250 μg/mL,配成含药PDB培养基,用移液枪移取10 mL浓度为1.0×107 CFU/mL的木霉孢子—芽孢菌体悬浮液,加入含有不同分散剂的150 mL母液中,空白对照为不加任何分散剂的PDB培养基,同样加入10 mL相同浓度的孢子悬浮液,摇匀后静置,经过0、4、8 h分别用移液枪从悬浮液上、中、下层取样,采用血球计数法测量孢子浓度,计算不同分散剂的分散指数[8],选择出分散效果较好的分散剂。按公式计算分散剂的分散指数(I分散):
式中:σ为标准差;A为样本平均数。
-
试验方法参照1.4.1。
-
取不同紫外保护剂1 000 μg/mL,分别配置含紫外保护剂的木霉孢子悬浮液和芽孢菌液,木霉孢子悬浮液浓度稀释至1.0×103 CFU/mL,芽孢菌液稀释到10-5。分别均匀涂布于PDA培养基平板上,参照文献[16]中设定的紫外处理方法,36 h后分别观察萌发形成的木霉孢子以及芽孢菌落数,以不加紫外保护剂、不经紫外灯照射的为对照1,计算理论活菌率;以不加紫外保护剂、经紫外灯照射的为对照2,计算残存活菌率)。选择出保护效能较高的紫外保护剂,保护效能指数(I保护)计算公式:
式中:R照射后为照射后活菌率;R残存为残存活菌率;R理论为理论活菌率。
-
完成单因素筛选后,采用L9(34)正交试验设计方案(表 1,表 2),以5 g为基数,木霉—芽孢菌粉、吐温-20、羧甲基纤维素钠、卵磷脂作为试验因素,其余用最佳载体白炭黑补足至100%。不同试验因素按常用质量分数设计3个水平,进行4因素3水平的正交试验。通过正交试验设计出各因素水平的组合方案,以润湿时间和悬浮率作为测定指标,每个处理3次重复,选择出WP的最佳助剂成分比例。
-
根据GB/T 5451—2001[13]、GB/T 14825—2023[14]、《农药粉剂、可湿性粉剂细度测定方法》 (GB/T 16150—1995)[17]、《农药pH值的测定方法》 (GB/T 1601—2023)[18]、《农药持久起泡性测定方法》 (GB/T 28137—2011)[19]的要求对木霉—芽孢WP的悬浮率、润湿时间、样品细度、pH值、起泡性等进行检测;并将可湿性粉剂溶于无菌水中,取100 μL合适稀释倍数的溶液涂平板检测活孢子数。
-
测试方法参考文献[20],略作改动。取1 g WP,无菌水稀释至50 mL;选取刚发芽的种子,保持5 mm左右间距放入铺有湿润滤纸的培养皿中,共分为1个对照组和3个试验组,9颗种子为1组。对照组接种无菌水,试验组分别接种1 mL可湿性粉剂WP稀释液、0.5 mL的纹枯菌悬液和0.5 mL无菌水、0.5 mL的纹枯菌悬液和0.5 mL可湿性粉剂稀释液。室温培养14 d后观察并测量株高及根长,重复3次。
-
称取1 g WP加入100 mL无菌水中,配制成浓度为0.01 g/mL的溶液,备用。将出芽一致的水稻种子播种至装有无菌泥土、高25 cm、长16 cm、宽16 cm的塑料盆中,置于温度30 ℃、相对湿度90%的温室中培养,待秧苗长至分蘖期时,在PDA平板上培养2 d的水稻纹枯病菌边缘取直径为6 mm的菌饼,将其用昆虫针固定接种到水稻基部以及叶部[21],2 d后分别用0.01 g/mL木霉—芽孢可湿性粉剂、4%井冈霉素300倍液、清水喷施水稻苗,直到叶片向下滴水为止。共设3个处理,每个处理3株,重复3次。药后14 d按照《农药田间药效试验准则(一)杀菌剂防治水稻纹枯病》 (GB/T 17980.20—2000)[22]中的方法记录病害严重度,计算病指与防效。
-
数据使用Excel 2019和SPSS 27.0软件进行相关分析,采用沃勒—邓肯法比较不同处理间的差异显著性(p<0.05),对正交试验进行极差分析和方差分析。
1.1. 供试材料
1.2. 木霉孢子、芽孢杆菌悬浮液以及水稻纹枯病菌悬液的制备
1.3. 木霉—芽孢共培养验证及菌粉的制备
1.4. 载体的筛选
1.4.1. 载体对T. breve LN006和B. velezensis ZJ生长量的影响
1.4.2. 载体润湿时间与悬浮率测定
1.4.3. 载体对孢子—菌体悬浮液的吸附作用
1.5. 润湿剂的筛选
1.5.1. 润湿剂对T. breve LN006和B. velezensis ZJ生长量的影响
1.5.2. 润湿剂的湿润性能测定
1.6. 分散剂的筛选
1.6.1. 分散剂对T. breve LN006和B. velezensis ZJ生长量的影响
1.6.2. 分散剂的分散指数测定
1.7. 紫外保护剂的筛选
1.7.1. 紫外保护剂对T. breve LN006和B. velezensis ZJ生长量的影响
1.7.2. 紫外保护剂的保护效能指数测定
1.8. 可湿性粉剂(WP)助剂成分比例的优化
1.9. 可湿性粉剂的质量检测
1.10. 可湿性粉剂对水稻幼芽的促生及防病效果
1.11. 室内盆栽防效测定
1.12. 统计学分析
-
T. breve LN006和B. velezensis ZJ在PDA平板上对峙培养显示,木霉与芽孢杆菌可以亲和共培养(图 1)。在固体培养基质上共培养结果显示,木霉产孢速度快,3 d时产生大量孢子;7 d后烘干、粉碎并过200目筛后,其木霉孢子数为7.51×109 CFU/g,芽孢活菌量为9.22×109 CFU/g(图 2)。
-
载体对T. breve LN006和B. velezensis ZJ菌丝生长的影响如表 3。T. breve LN006在不同的载体培养基上生长2 d后,除滑石粉外其余4种载体均不抑制菌丝生长。B. velezensis ZJ在不同的载体培养基上生长2 d后,高岭土、滑石粉抑制生长,膨润土、白炭黑、硅藻土对菌落生长有促进作用。
-
载体的悬浮率越高,润湿时间越短,载体的性能越好。5种供试载体中,白炭黑的悬浮率最高,为77.86%,高于其他筛选载体(图 3)。润湿时间最短的是硅藻土,为11.76 s(图 4),其他载体润湿时间由短到长依次为:高岭土(13.78 s)、白炭黑(38.94 s)、膨润土(45.09 s)、滑石粉(60.71 s)。综合分析得出,白炭黑和膨润土的性能较好。
-
5种载体对木霉—芽孢菌体悬浮液都具有一定的吸附力。白炭黑吸附率最高,为3.40,且与其余4种载体相比差异有统计学意义,证明白炭黑的吸附力最强;其次是硅藻土,为1.95;吸附率最低的是膨润土,为0.59(图 5)。综合分析得出,硅藻土和白炭黑的吸附率较高、吸附力较强。结合前期的试验结果,选择白炭黑作为T. breve LN006和B. velezensis ZJ WP的最佳载体。
-
结果如表 4,T. breve LN006在不同的含药培养基上生长2 d后,十二烷基硫酸钠、十二烷基苯磺酸钠、拉开粉对T. breve LN006和B. velezensis ZJ抑制率为100%,吐温-80可促进T. breve LN006菌丝的生长但强烈抑制B. velezensis ZJ菌落的形成。甲基纤维素、吐温-20对B. velezensis ZJ生长影响小,与对照差异无统计学意义;对T. breve LN006的生长有中等程度的抑制作用,但木霉菌丝仍可在5 d内长满平板。
-
润湿剂的润湿时间越短,湿润性能越好。吐温-20的润湿时间最短,为36 s;十二烷基苯磺酸钠的润湿时间最长,为52.23 s(图 6)。结果显示,吐温-20和吐温-80的湿润性能相对较好,结合前期的试验结果,选择吐温-20作为T. breve LN006和B. velezensis ZJ WP的最佳润湿剂。
-
T. breve LN006在不同的含药培养基上生长2 d后,木质素磺酸钙、羧甲基纤维素钠对菌丝生长的影响较小,与对照差异无统计学意义(表 5)。B. velezensis ZJ在不同的含药培养基上生长2 d后,对生长量影响最小的载体为聚乙烯醇,其次为羧甲基纤维素钠,与对照差异有统计学意义。BB4完全抑制了B. velezensis ZJ的生长。羧甲基纤维素钠对T. breve LN006和B. velezensis ZJ生长的影响均较小,可作为本制剂中的分散剂。
-
不同分散剂对孢悬液孢子的分散效力不同,但总体上能促进孢子分散。在0~8 h,与对照相比,分散指数随着静置时间的增加,孢子分布由均匀分布向随机分布发展;在含有5种不同分散剂的母液中,BB4的分散性能最佳,在8 h时的分散指数为0.53,随着时间的增加呈均匀分布;其次是羧甲基纤维素钠,8 h的分散指数为0.72(表 6)。综合分析得出,BB4和羧甲基纤维素钠的分散性能较好,结合前期试验结果,选择羧甲基纤维素钠为T. breve LN006和B. velezensis ZJ WP的最佳分散剂。
-
T. breve LN006在不同的含药培养基上生长2 d后,卵磷脂和荧光素钠与对照相比差异无统计学意义,说明其不抑制菌丝的生长。B. velezensis ZJ在不同的含药培养基生长2 d后,维生素C完全抑制了B. velezensis ZJ的生长,黄原胶和卵磷脂对B. velezensis ZJ生长的影响较小(表 7)。
-
不同紫外保护剂的保护效能指数存在显著差异,维生素C对于T. breve LN006的保护效能指数最高,达到0.27,与其他4种紫外保护剂相比差异明显,说明维生素C可明显抑制紫外光对孢子的杀伤作用;其次是卵磷脂,保护效能指数为0.12;其余3种紫外保护剂的保护效能较低(表 8)。卵磷脂对于B. velezensis ZJ的保护效能指数最高,达到0.21。综合分析得出,卵磷脂的保护能力较好,结合前期的试验结果,可选择卵磷脂作为T. breve LN006和B. velezensis ZJ WP的最佳紫外保护剂。
-
在确定T. breve LN006和B. velezensis ZJ最佳助剂种类的基础上,进行正交优化试验,研究不同助剂成分比例对T. breve LN006和B. velezensis ZJ WP悬浮率和润湿时间的影响,结果见表 9。4个因素的极差R值存在差异,各因素对T. breve LN006和B. velezensis ZJ WP润湿时间的影响大小通过R值反应,R值越大,则表明该因素对润湿时间的影响程度越大,反之则越小。结果显示,对T. breve LN006和B. velezensis ZJ WP润湿时间的影响为A>C>B>D,即菌粉对WP的润湿时间影响最大,其次为羧甲基纤维素钠、吐温-20、卵磷脂。
对悬浮率试验结果进行数据统计分析,结果显示,4个因素的极差R值存在差异,各因素对T. breve LN006和B. velezensis ZJ WP悬浮率的影响程度为A>B>C>D,即菌粉对WP悬浮率的影响最大,其次为吐温-20、羧甲基纤维素钠、卵磷脂(表 10)。
助剂成分比例筛选结果表明,T. breve LN006和B. velezensis ZJ WP各个助剂最佳组合为A3B3C2D3,即菌粉20%,吐温-20 5%,羧甲基纤维素钠8%,卵磷脂0.4%,其余66.6%用载体白炭黑补足,制成T. breve LN006和B. velezensis ZJ WP。
-
经测定,T. breve LN006和B. velezensis ZJ WP湿润时间为41.72±2.69 s,悬浮率为87.79%±3.15%,pH值为7.11±0.03,200目筛的通过率为95.77%±1.32%,木霉活孢子数为1.45×109 CFU/g,芽孢活菌量为1.78×109 CFU/g,起泡性为14±3.06 mL。
-
T. breve LN006和B. velezensis ZJ WP对水稻幼芽有促生作用,其根长与株高均高于清水对照组。由图 7、图 8可知,WP株高为5.73 cm,根长为5.91 cm,与对照相比分别增长了18.67%和10.47%。与水稻纹枯病菌摇菌液单独处理相比,WP与水稻纹枯病菌摇菌液共同处理的水稻根长与株高也明显增加。
-
T. breve LN006和B. velezensis ZJ WP与井冈霉素对水稻纹枯病均有较好的盆栽防效,分别为65.12%和72.09%(表 11),两处理间差异无统计学意义。
2.1. 木霉—芽孢共培养验证及菌粉的制备
2.2. T. breve LN006和B. velezensis ZJ共培养载体的筛选
2.2.1. 载体对T. breve LN006和B. velezensis ZJ生长量的影响
2.2.2. 载体润湿时间与悬浮率测定
2.2.3. 载体对木霉—芽孢菌体悬浮液的吸附作用
2.3. 润湿剂的筛选
2.3.1. 润湿剂对T. breve LN006和B. velezensis ZJ生长量的影响
2.3.2. 润湿剂的湿润性能测定结果
2.4. 分散剂的筛选
2.4.1. 分散剂对T. breve LN006和B. velezensis ZJ生长量的影响
2.4.2. 分散剂的分散指数测定结果
2.5. 紫外保护剂的筛选
2.5.1. 紫外保护剂对T. breve LN006和B. velezensis ZJ生长量的影响
2.5.2. 紫外保护剂的保护效能
2.6. WP助剂成分比例的优化
2.7. 可湿性粉剂的质量检测
2.8. 可湿性粉剂对水稻幼芽的促生效果
2.9. 可湿性粉剂室内盆栽防效测定
-
水稻纹枯病是水稻的重要病害,化学防效受雨量、湿度等天气因素影响较大,且需配合排水晒田等措施才能达到较好防效,因此,利用生物防治探索纹枯病的防治新途径非常必要。本文研究不同载体、润湿剂、分散剂、紫外保护剂与T. breve LN006和B. velezensis ZJ的生物相容性,并结合载体的吸附力、润湿剂的湿润性能、分散剂的分散指数、紫外保护剂的保护效能等试验因素,成功制备了含有木霉菌和芽孢杆菌固体共培养物的可湿性粉剂。制剂悬浮率符合可湿性粉剂的要求,初步测定菌剂的盆栽试验防效为65.12%,且对水稻有促生作用。
可湿性粉剂是微生物农药的重要剂型,不同生防菌株与可湿性粉剂不同助剂之间生物相容性差异也很大。在T. breve LN006和B. velezensis ZJ WP中,吐温-20 5%,羧甲基纤维素钠8%,卵磷脂0.4%,白炭黑66.6%,与两种生防菌相容性较好。白炭黑是农药水悬浮剂等制剂的重要载体,枯草芽孢杆菌JN005可湿性粉剂[23]、甲基营养型芽孢杆菌NKG-1可湿性粉剂[24]的载体均为白炭黑。吐温-20在木霉菌剂制备中可用作润湿剂[25],加入一定含量的润湿剂可使其快速润湿。分散剂羧甲基纤维素钠具有增稠、成膜、乳化和悬浮等特性,可以提高可湿性粉剂的悬浮率[26]。对T. breve LN006紫外保护效果最好的是维生素C,但在使用浓度下完全抑制了B. velezensis ZJ的生长。康氏木霉KS WP的研制中[11],维生素C的紫外保护效能最高,卵磷脂次之,其结论与本研究相似。不同紫外保护剂对不同波长紫外线吸收度不尽相同,可进一步试验筛选不同保护剂进行组合应用。参照化学农药制作方法制备微生物农药时,存在菌种活力下降较快等问题,木霉与亲和芽孢杆菌WP由于含有一定数量的谷物培养基,其中稻壳生产过程中含有残留的淀粉、纤维素和半纤维素,以及其本身含有丰富的微量元素[27],有利于菌种在制剂中存活。另外,制剂喷洒到作物叶面后,其自身能提供菌体初始萌发生长所需的营养,有利于活体微生物在叶面的迅速定殖及菌剂防效的发挥。
木霉与芽孢杆菌是应用比较广泛的生防微生物,且可通过促根作用来促进水稻幼苗的生长[28]。共培养时可通过微生物间互作产生新型代谢物,木霉与细菌之间的协同作用带来的好处大于它们各自的作用之和,其组合作为植物生长促进剂和生防菌剂的作用机制更加多样化,应用潜力更大[4]。本研究通过筛选亲和菌株、时序接种等方式平衡木霉与芽孢杆菌共培养过程中的生长难题,并做出了有益的尝试。T. breve LN006和B. velezensis ZJ WP对水稻安全,全生长期都可使用。海南每年第二造水稻在11-12月留茬收割,此时段再生稻株上容易感染纹枯等病害,在稻茬上喷洒菌剂,一方面菌剂中的木霉可加速稻茬纤维素的降解,加快有机质还田,提高土壤肥力、抗氧化以及土壤污染修复[29]等;另一方面,菌剂在水稻田中的扩繁可抑制纹枯病菌的越冬菌量,为水稻纹枯病可持续防控提供了一条新的途径。制剂中加入亲和绿僵菌等微生物,可达到水稻害虫协同绿色防控的目的,减少了施药次数,有较好的应用前景,值得进一步试验并加以推广。

下载:
下载:






